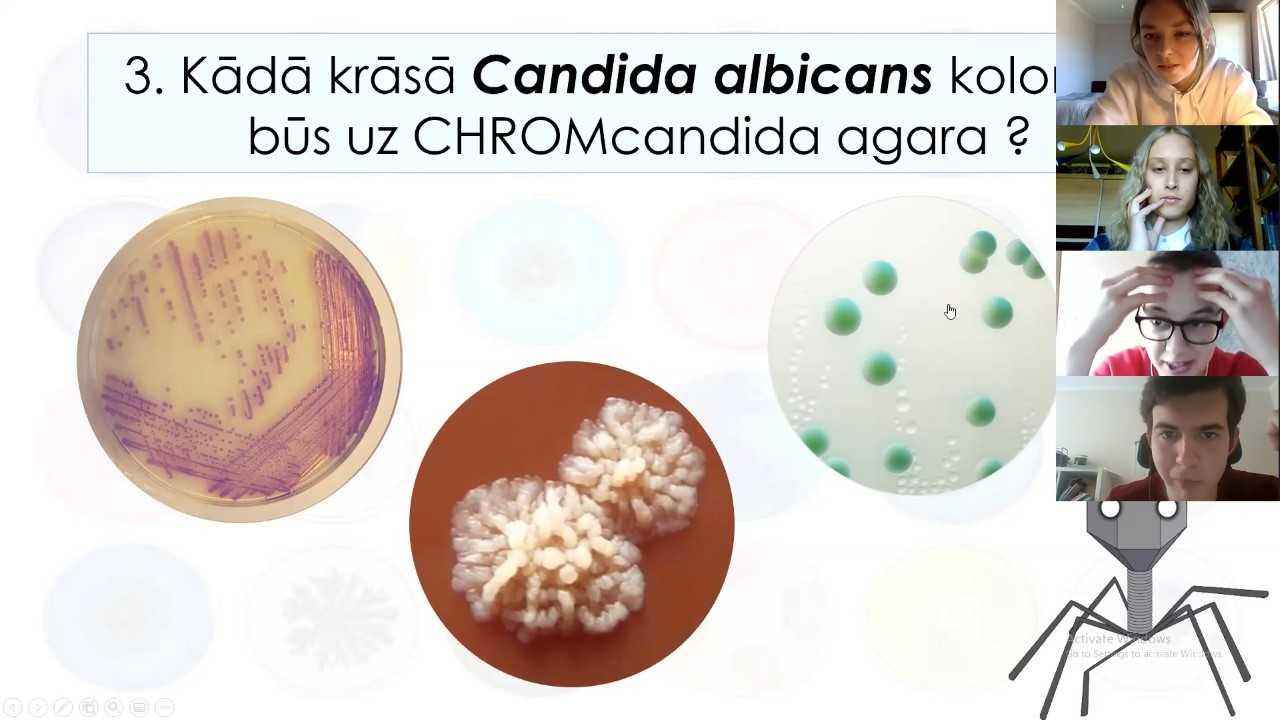

Aizvadīta mikrobioloģijas olimpiāde "12 kg kultūras"
Sestdien, 23. maijā, ar plašu dalībnieku un viesu skaitu tiešsaistes platformā Zoom norisinājās Rīgas Stradiņa universitātes (RSU) Mikrobioloģijas zinātniskā pulciņa olimpiāde 12 kg kultūras. Tajā piedalījās 18 komandas, pulcējot vairāk nekā 70 dalībnieku un pārstāvot studentus no 1., 2. un 3. kursa.
Studentiem bija ne vien jāpierāda iegūtās zināšanas mikrobioloģijā, bet arī jāatsauc atmiņā dažādi vēstures fakti, jāatšifrē slepenie kodi, kā arī radošā veidā jāatmin ar imunoloģiju saistīti termini. Komandām pirms olimpiādes bija jāsagatavo mājasdarbs – mēme (meme) par mikrobioloģijas tēmu, ko izvērtēja neatkarīga žūrija prof. Jutas Kroičas vadībā.
"Lai gan ir pulcēšanās ierobežojumi, Mikrobioloģijas olimpiādes organizētāju komanda veiksmīgi spēja pārnest sākotnēji plānoto klātienes olimpiādi uz virtuālo vidi. Interaktīvā veidā ar nestandarta uzdevumiem pārbaudījām studentu plašās mikrobioloģijas zināšanas un pārliecinājāmies, ka jaunieši lieliski arī virtuālajā vidē spēj sastrādāties komandā, strādājot pie viena uzdevuma ierobežotā laikā. Kā atzina studenti, šī bija lieliska iespēja saliedēties un pavadīt laiku ar kursabiedriem ārkārtas situācijas apstākļos, kad tikšanās klātienē ir ļoti ierobežota," stāsta Medicīnas fakultātes (MF) prodekāns doc. Ingus Skadiņš.
Iedvesmojošus vārdus pirms olimpiādes teica MF dekāne asoc. prof. Jana Pavāre, veselības studiju prorektors prof. Guntis Bahs un Zinātnes departamenta direktore Liene Ņikitina-Zaķe. Olimpiādi par atklātu pasludināja Bioloģijas un mikrobioloģijas katedras vadītāja prof. Juta Kroiča.
Olimpiādes veiksmīgu norisi nodrošināja projekta vadītāja Aleksandra Kamenska un pulciņa vadītājs Aleksandrs Dorogojs, kā arī Mikrobioloģijas pulciņa apmeklētāji un biedri: Dārta Jakovicka, Katrīna Tomiņa, Ulrika Ulla Andersone, Liliāna Ilgača, Viktorija Aleksejeva, Margarita Gerasimova, Terēze Pavloviča, Kirils Jeršovs, Vladimirs Krutovs, Niks Ričards Goldiņš. Īpaši liela pateicība izsakāma Bioloģijas un mikrobioloģijas katedrai, tai skaitā Anastasijai Dovbenko un pulciņa mentoram doc. Ingum Skadiņam.
Par sadarbību un vērtīgām balvām dalībniekiem pateicamies RSU Bioloģijas un mikrobioloģijas katedrai, žurnālam Doctus, SushiClub.lv un AM Sushi.
Olimpiādes 12 kg kultūras uzvarētāji
- 1. vieta
We can’t B. cereus (2. kursa studenti Kristīne Kalēja, Artūrs Sokolovskis, Renārs Pētersons, Līva Auziņa) - 2. vieta
Friendship (2. kursa studenti Arnis Birze, Pēteris Grīnbergs, Estere Moorlata, Gustavs Gūtmanis) - 3. vieta
Tuberkuloze2020 (3. kursa studenti Madara Ratniece, Katrīna Freimane, Ivo Siņicins, Matīss Šņukuts)
Labākais sagatavotais mājasdarbs
- Species Squad (2. kursa studenti Sāra Dūniņa, Undīne Kreitūze, Alise Fjodorova, Marika Āboliņa)
Saistītās ziņas
Endokrinoloģijas olimpiādē "Dzīves hormons" piekto gadu pēc kārtas triumfē RSU studentiTradicionālie pasākumi, Studentiem